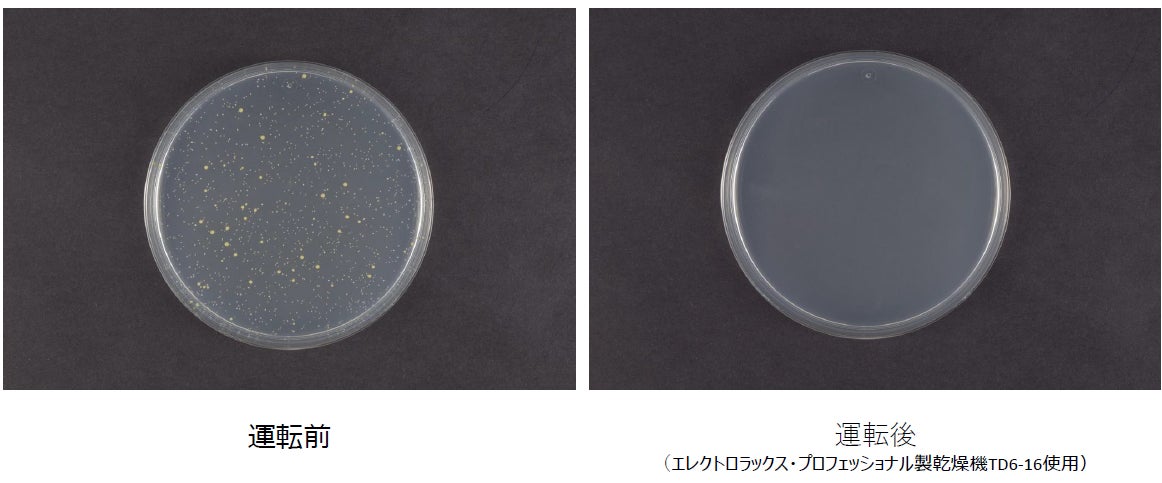

【共同リリース】家庭内の衣類や寝具に、清潔品質をプラス!
プラズマクラスターイオン発生ユニットを搭載した業務用乾燥機、業務用洗濯乾燥機をエレクトロラックス・プロフェッショナル・ジャパンと山本製作所が、コインランドリー市場向けに発売

エレクトロラックス・プロフェッショナル・ジャパン株式会社
株式会社山本製作所
株式会社wash-plus
シャープ株式会社

※ 左:山本製作所製、 右:エレクトロラックス・プロフェッショナル製
エレクトロラックス・プロフェッショナル・ジャパン株式会社(本社:東京都港区)、株式会社山本製作所(本社:広島県尾道市)、株式会社wash-plus(本社:千葉県浦安市)は、シャープ株式会社(本社:大阪府堺市)が提供するプラズマクラスターイオン発生ユニットを搭載した業務用乾燥機、業務用洗濯乾燥機を共同で企画し、コインランドリー市場に向けエレクトロラックス・プロフェッショナル・ジャパンおよび山本製作所より本年6月に発売いたします。
コインランドリーは近年、家事の時短化や衣類のカジュアル化などの需要を受け、利用者が増加しています。現在、日本国内にコインランドリー店舗は約23,000店舗(ゼンドラ株式会社調べ)あり、店舗数も増加傾向にあります。また、ニューノーマルの定着により消費者の清潔志向も高まっており、より清潔な環境での生活が求められています。
このたび、プラズマクラスターイオン発生ユニット搭載の業務用乾燥機、業務用洗濯乾燥機の除菌*1・静電気抑制*2効果について、シャープ株式会社による評価試験により、初めて*3その効果が実証されました。
乾燥運転時にプラズマクラスターイオンを放出し、ドラム内の衣類や寝具を除菌します。また、静電気抑制効果により乾燥運転時の静電気を減らし、洗濯物を取り出す際の「パチッ」を抑えます。
プラズマクラスターイオン発生ユニットを搭載した業務用乾燥機、業務用洗濯乾燥機の実証された効果により、コインランドリー利用者に、より快適にご利用いただける環境を提供してまいります。
【各社の役割】

| 社名 | 役割 |
| エレクトロラックス・プロフェッショナル・ジャパン株式会社 | 業務用乾燥機、業務用洗濯乾燥機の製造、販売、コインランドリー事業展開 |
| 株式会社山本製作所 | 業務用乾燥機、業務用洗濯乾燥機の製造、販売、コインランドリー事業展開 |
| 株式会社 wash-plus | ランドリー事業者、オリジナル洗濯乾燥機・乾燥機の企画開発、ランドリーシステム企画開発 |
| シャープ株式会社 | プラズマクラスターイオン発生ユニットの提供、イオン濃度最適化検討、実機による除菌試験、実機による静電気抑制試験 |
【プラズマクラスターイオン発生ユニット搭載による除菌効果・静電気抑制効果】
プラズマクラスターイオン発生ユニットが搭載された業務用乾燥機および業務用洗濯乾燥機の実機を用いて除菌性能の有無を評価試験した結果、エレクトロラックス・プロフェッショナル製、山本製作所製の計13機種*4において、いずれも99%以上の除菌性能が実証されました。また、静電気抑制効果についても、39%~86.5%の静電気量の低減効果が認められました。
■*1除菌効果について(代表機種について記載)

| 検査試験の概要 | プラズマクラスターイオン発生ユニットが搭載された業務用乾燥機および業務用洗濯乾燥機の実機を用いて、除菌性能の有無を評価する試験を実施。 |
| 試験方法 | 菌を付着させた試験布を乾燥運転(業務用乾燥機)、洗濯~乾燥運転(業務用洗濯乾燥機)した際の菌の減少率を測定。 【業務用乾燥機】 山本製作所製:VG142C乾燥運転7kg エレクトロラックス・プロフェッショナル製:TD6-16乾燥運転16kg 【業務用洗濯乾燥機】 山本製作所製:WD120CS洗濯~乾燥運転4kg |
| 除菌方法 | 【業務用乾燥機】プラズマクラスターおよび乾燥運転による 【業務用洗濯乾燥機】プラズマクラスターおよび洗濯~乾燥運転による |
| 対象部分 | ドラム内の衣類 |
| 試験結果 | 評価試験を実施した13機種(山本製作所製7機種、エレクトロラックス・プロフェッショナル製6機種)において、いずれも99%以上抑制。乾燥運転時にプラズマクラスターイオンが供給される洗濯槽内における38分後の効果 |
| イオン濃度 | 【業務用乾燥機】 山本製作所製:VG142C 約37万個/cm3 エレクトロラックス・プロフェッショナル製:TD6-16 約47万個/cm3 【業務用洗濯乾燥機】 山本製作所製:WD120CS約36万個/cm3 |
| 試験機種 | 各機種にプラズマクラスターイオン発生ユニットを設置した試験機 |
| 試験実施 | シャープ株式会社 |
| 試験機関 | (一財)日本食品分析センター試験成績書番号:第22001416001-0101号 |
■*2静電気抑制効果について(代表機種について記載)

| 検査試験の概要 | プラズマクラスターイオン発生ユニットが搭載された、業務用乾燥機および業務用洗濯乾燥機の実機を用いて、静電気量低減効果の有無を評価する試験を実施。 |
| 試験方法 | 各機種にプラズマクラスーイオン発生ユニットを設置した試験機にて実施。乾燥運転時、化学繊維100%の衣類において、プラズマクラスター送風無し(以下PCI送風無)とプラズマクラスター送風有(以下PCI送風有)の場合を比べた時の静電気量の低減量を測定。 |
| 試験結果 | 【業務用乾燥機】 エレクトロラックス・プロフェッショナル製:乾燥運転時における10分後の 効果。 TD6-16 約60.9%低減(PCI送風無4.68kV→PCI送付有1.83kV) 【業務用洗濯乾燥機】 山本製作所製:乾燥運転時における12分後の効果。 WD120CS 約53%低減(PCI送風無4.1kV→PCI送付有2.03kV) |
| 試験実施 | シャープ株式会社 |
*3 国内で販売する業務用乾燥機、業務用洗濯乾燥機において、プラズマクラスターイオン発生ユニット搭載による乾燥運転時の除菌効果、静電気抑制効果の評価試験を、実機を用いて実施。2022年4月13日現在。
*4 対象機種と機種ごとの試験結果については、各社(エレクトロラックス・プロフェッショナル・ジャパンまたは山本製作所)までお問い合わせください。
<エレクトロラックス・プロフェッショナル・ジャパン株式会社>
本社:東京都港区芝大門2-5-5 住友芝大門ビル4F
代表取締役社長:城戸 良行
ウェブサイト:https://www.electroluxprofessional.com/jp/
コインランドリー専用サイト:https://laundream.com
電話番号:0120-593-381(フリーダイヤル)
<株式会社山本製作所>
本社:広島県尾道市長者原1丁目220-19
代表取締役社長:山本 尚平
ウェブサイト:https://www.onomichi-yamamoto.co.jp/
電話番号:0848-48-5300
<株式会社wash-plus>
本社:千葉県浦安市猫実1-9-5
代表取締役:高梨 健太郎
ウェブサイト:https://www.wash-plus.jp/
<シャープ株式会社>
本社:大阪府堺市堺区匠町1番地
代表取締役社長:野村 勝明
ウェブサイト:https://corporate.jp.sharp/
このプレスリリースには、メディア関係者向けの情報があります
メディアユーザーログイン既に登録済みの方はこちら
メディアユーザー登録を行うと、企業担当者の連絡先や、イベント・記者会見の情報など様々な特記情報を閲覧できます。※内容はプレスリリースにより異なります。
すべての画像
